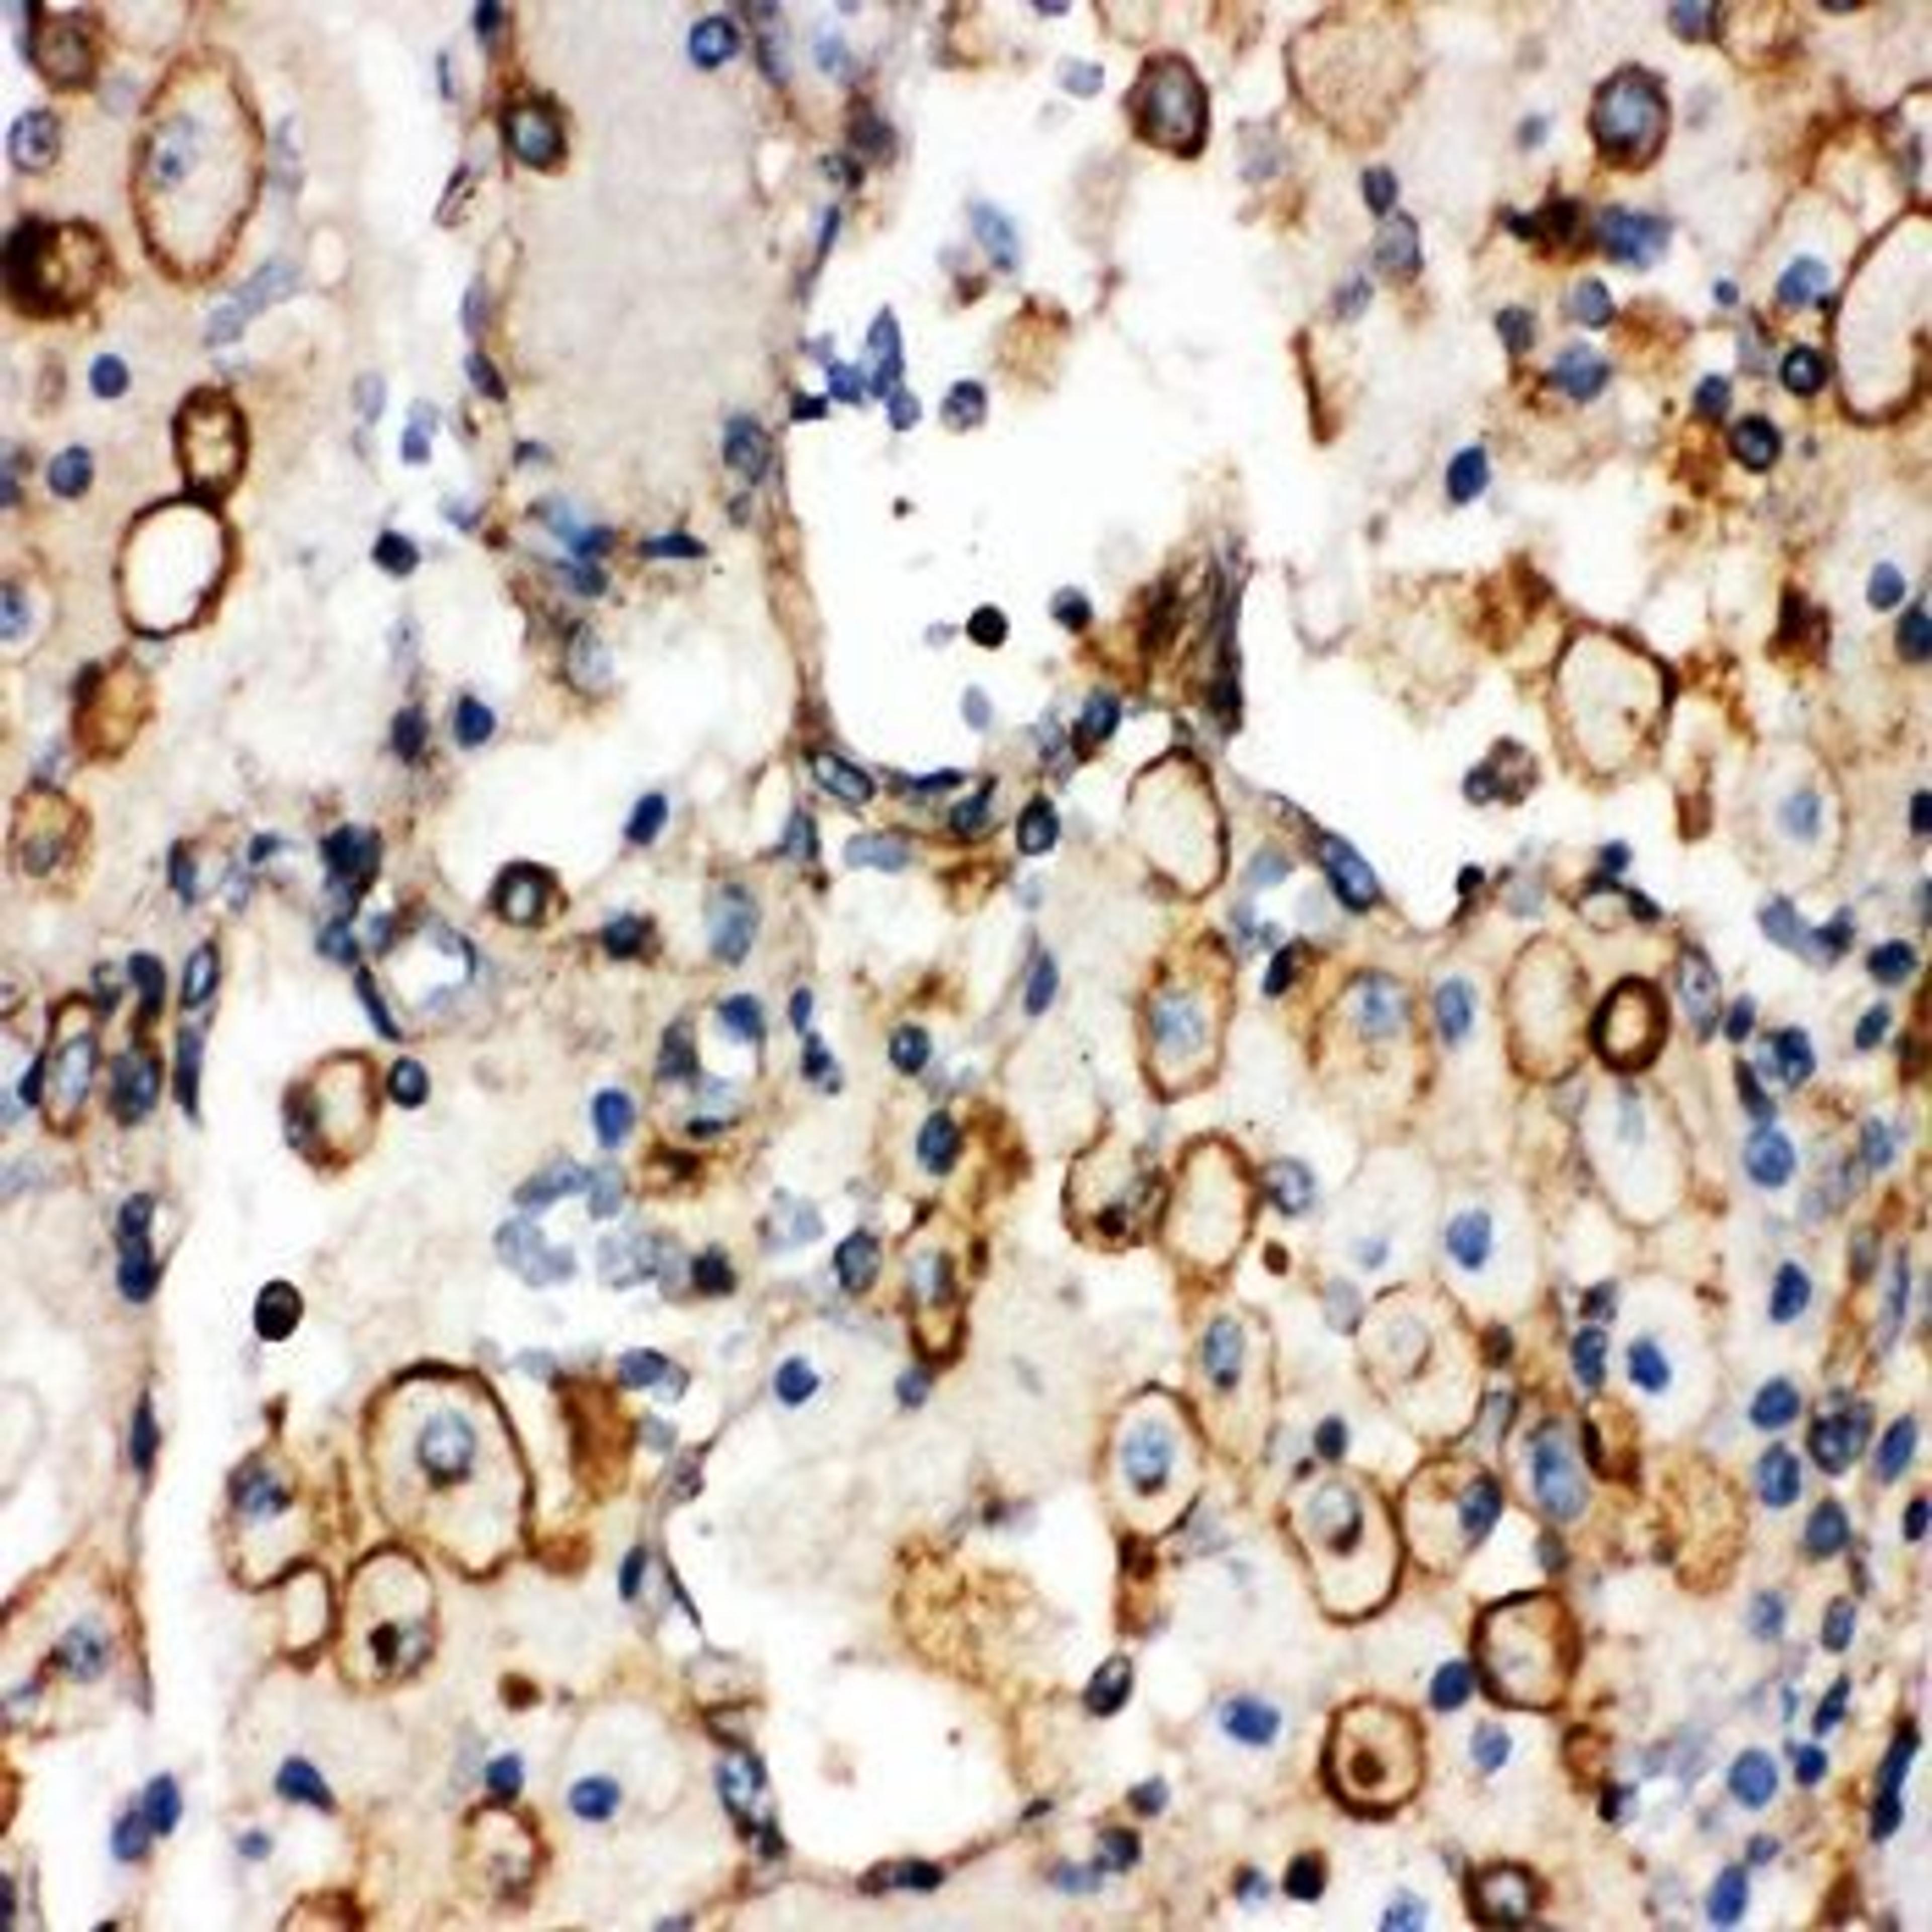
Immunohistochemical analysis of formalin-fixed paraffin embedded Human Lung Cancer Tissue using ITGA1 antibody

Product & ReviewsAntibodies
SLC12A2 antibody
Product Details
- Cat. No.
- orb137940
- Type
- Primary Antibody
- Clonality
- Polyclonal
- Host
- Rabbit

The supplier does not provide quotations for this antibody through SelectScience. You can search for similar antibodies in our Antibody Directory.
Description
Rabbit polyclonal to SLC12A2. Solute carrier family 12 (sodium/potassium/chloride transporters), member 2, also known as NKCC1, is widely distributed throughout the body, especially in organs that secrete fluids, called exocrine glands. By fluorescence in
Biological Information
- Clonality: Polyclonal
- Host: Rabbit
- Reactivity: Human, Mammalian, Mouse
- Isotype: IgG
Handling
- Quantity: 100 µg
- Storage: Store at 2-8°C and -20°C for one year. (Shipped on ice packs)
- Buffer: PBS pH 7.4, 50% glycerol, 0.1% sodium azide
Applications
- Immunohistochemistry (Frozen Sections) (IHC (Fr))
- Immunohistochemistry (Paraffin-Embedded Sections) (IHC (P))
- Western Blotting (WB)